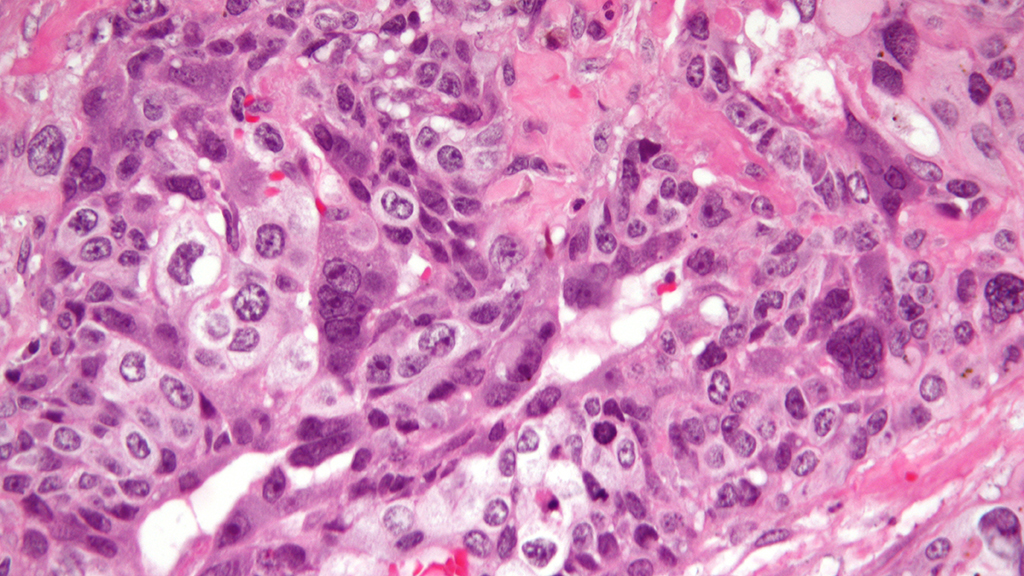

Abstract
This case is based on the true story of a woman with choriocarcinoma, a rare type of rapidly dividing and metastatic cancer derived from cells of the placenta. The case begins with Yvette being admitted to a hospital due to neurological irregularities. Blood tests indicate that she is pregnant, but an ultrasound shows that she is not. Ultimately she learns that she has cancer that has metastasized to her liver, lungs, and brain. Since the cancer cells are derived from placental cells, they produce human chorionic gonadotropin hormone (hCG), the hormone detected in traditional pregnancy tests. The case follows Yvette through chemotherapeutic and radiation treatments. Students learn about tumor formation and metastases as well as cancer treatment and the side-effects of radiation therapy and chemotherapy. Originally designed for use in undergraduate biology, biochemistry, or pre-health courses to teach students about cancer cell biology, this case could also be used to introduce more advanced topics on cell cycle or endocrinology in upper-level courses with junior and senior science or pre-health students.